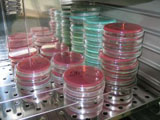

СЭС Малиновского района(бактериологическая лаборатория)
Рейтинг заведения
1.0
Очень хорошо
0
Хорошо
0
Неплохо
0
Плохо
0
Ужасно
1
О компании
Для предприятия отсутствует описание
Давайте улучшим справочник 💪
Не получается внести правки? Свяжитесь с нашим редактором справочника в Telegram
Компании рядом
Загрузка...

Facebook
Facebook Google +
Google +
